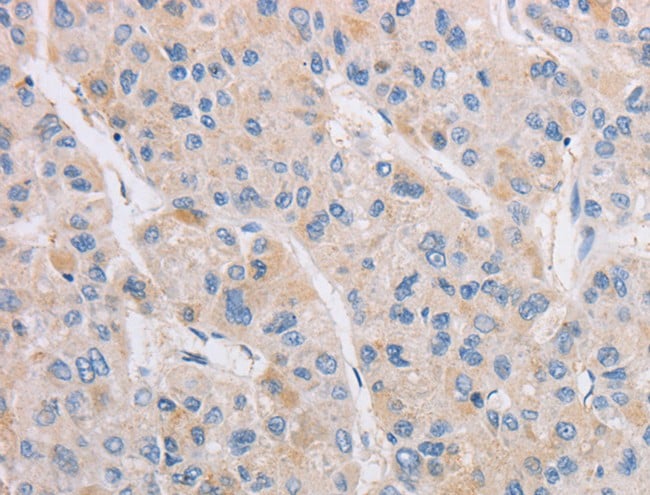
product-image-AAA166413_IHC13.jpg
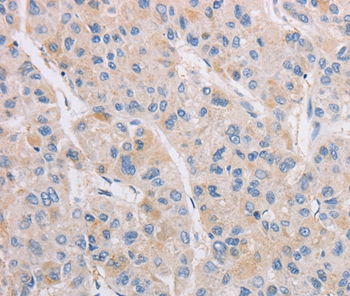
product-image-AAA303374_IHC13.jpg

Histone acetyltransferase KAT5 Recombinant Protein | KAT5 recombinant protein
Recombinant Human Histone acetyltransferase KAT5
Gene Names
KAT5; TIP; ESA1; PLIP; TIP60; cPLA2; HTATIP; ZC2HC5; HTATIP1
Purity
Greater or equal to 85% purity as determined by SDS-PAGE.
Synonyms
Histone acetyltransferase KAT5; N/A; Recombinant Human Histone acetyltransferase KAT5; 60 kDa Tat-interactive protein; Tip60; Histone acetyltransferase HTATIP; HIV-1 Tat interactive protein; Lysine acetyltransferase 5cPLA(2)-interacting protein; KAT5 recombinant protein
Host
E Coli
Purity/Purification
Greater or equal to 85% purity as determined by SDS-PAGE.
Form/Format
Liquid containing glycerol
Sequence Positions
3-513. Partial
Sequence
EVGEIIEGCRLPVLRRNQDNEDEWPLAEILSVKDISGRKLFYVHYIDFNKRLDEWVTHERLDLKKIQFPKKEAKTPTKNGLPGSRPGSPEREVPASAQASGKTLPIPVQITLRFNLPKEREAIPGGEPDQPLSSSSCLQPNHRSTKRKVEVVSPATPVPSETAPASVFPQNGAARRAVAAQPGRKRKSNCLGTDEDSQDSSDGIPSAPRMTGSLVSDRSHDDIVTRMKNIECIELGRHRLKPWYFSPYPQELTTLPVLYLCEFCLKYGRSLKCLQRHLTKCDLRHPPGNEIYRKGTISFFEIDGRKNKSYSQNLCLLAKCFLDHKTLYYDTDPFLFYVMTEYDCKGFHIVGYFSKEKESTEDYNVACILTLPPYQRRGYGKLLIEFSYELSKVEGKTGTPEKPLSDLGLLSYRSYWSQTILEILMGLKSESGERPQITINEISEITSIKKEDVISTLQYLNLINYYKGQYILTLSEDIVDGHERAMLKRLLRIDSKCLHFTPKDWSKRGKW
Production Note
Special Offer: The E Coli host-expressed protein is manufactured from a stock plasmid containing the protein gene. E Colihost-expressed protein is stocked in different unit sizes ranging from as small as 10 ug to as large as 1 mg. Bulk inventory is also available. The E Coli host-expressed protein has been ordered over and over again by researchers and has stood the test of time as both a robust protein and important target for the research community. It is part of our new program to make our most popular protein targets and corresponding hosts available in expanded unit sizes and with a quick processing time. Select E Coli host-expressed protein for the fastest delivery among all hosts. Please contact our or email to for more details.
Preparation and Storage
Store at -20 degree C, for extended storage, conserve at -20 degree C or -80 degree C.
Related Product Information for KAT5 recombinant protein
Catalytic subunit of the NuA4 histone acetyltransferase complex which is involved in transcriptional activation of select genes principally by acetylation of nucleosomal histones H4 and H2A. This modification may both alter nucleosome-DNA interactions and promote interaction of the modified histones with other proteins which positively regulate transcription. This complex may be required for the activation of transcriptional programs associated with oncogene and proto-oncogene mediated growth induction, tumor suppressor mediated growth arrest and replicative senescence, apoptosis, and DNA repair. NuA4 may also play a direct role in DNA repair when recruited to sites of DNA damage. Directly acetylates and activates ATM. Component of a SWR1-like complex that specifically mediates the roval of histone H2A. Z/H2AFZ from the nucleosome. In case of HIV-1 infection, interaction with the viral Tat protein leads to KAT5 polyubiquitination and targets it to degradation. Relieves NR1D2-mediated inhibition of APOC3 expression by acetylating NR1D2. Promotes FOXP3 acetylation and positively regulates its transcriptional repressor activity
Product Categories/Family for KAT5 recombinant protein
References
Identification of a cellular protein that specifically interacts with the essential cysteine region of the HIV-1 Tat transactivator.Kamine J., Elangovan B., Subramanian T., Coleman D., Chinnadurai G.Virology 216:357-366(1996) PLIP, a novel splice variant of Tip60, interacts with group IV cytosolic phospholipase A(2) , induces apoptosis, and potentiates prostaglandin production.Sheridan A.M., Force T., Yoon H.J., O'Leary E., Choukroun G., Taheri M.R., Bonventre J.V.Mol. Cell. Biol. 21:4470-4481(2001) Identification of a larger form of the histone acetyl transferase Tip60.Legube G., Trouche D.Gene 310:161-168(2003) NIEHS SNPs programComplete sequencing and characterization of 21,243 full-length human cDNAs.Ota T., Suzuki Y., Nishikawa T., Otsuki T., Sugiyama T., Irie R., Wakamatsu A., Hayashi K., Sato H., Nagai K., Kimura K., Makita H., Sekine M., Obayashi M., Nishi T., Shibahara T., Tanaka T., Ishii S., Yamamoto J., Saito K., Kawai Y., Isono Y., Nakamura Y., Nagahari K., Murakami K., Yasuda T., Iwayanagi T., Wagatsuma M., Shiratori A., Sudo H., Hosoiri T., Kaku Y., Kodaira H., Kondo H., Sugawara M., Takahashi M., Kanda K., Yokoi T., Furuya T., Kikkawa E., Omura Y., Abe K., Kamihara K., Katsuta N., Sato K., Tanikawa M., Yamazaki M., Ninomiya K., Ishibashi T., Yamashita H., Murakawa K., Fujimori K., Tanai H., Kimata M., Watanabe M., Hiraoka S., Chiba Y., Ishida S., Ono Y., Takiguchi S., Watanabe S., Yosida M., Hotuta T., Kusano J., Kanehori K., Takahashi-Fujii A., Hara H., Tanase T.-O., Nomura Y., Togiya S., Komai F., Hara R., Takeuchi K., Arita M., Imose N., Musashino K., Yuuki H., Oshima A., Sasaki N., Aotsuka S., Yoshikawa Y., Matsunawa H., Ichihara T., Shiohata N., Sano S., Moriya S., Momiyama H., Satoh N., Takami S., Terashima Y., Suzuki O., Nakagawa S., Senoh A., Mizoguchi H., Goto Y., Shimizu F., Wakebe H., Hishigaki H., Watanabe T., Sugiyama A., Takemoto M., Kawakami B., Yamazaki M., Watanabe K., Kumagai A., Itakura S., Fukuzumi Y., Fujimori Y., Komiyama M., Tashiro H., Tanigami A., Fujiwara T., Ono T., Yamada K., Fujii Y., Ozaki K., Hirao M., Ohmori Y., Kawabata A., Hikiji T., Kobatake N., Inagaki H., Ikema Y., Okamoto S., Okitani R., Kawakami T., Noguchi S., Itoh T., Shigeta K., Senba T., Matsumura K., Nakajima Y., Mizuno T., Morinaga M., Sasaki M., Togashi T., Oyama M., Hata H., Watanabe M., Komatsu T., Mizushima-Sugano J., Satoh T., Shirai Y., Takahashi Y., Nakagawa K., Okumura K., Nagase T., Nomura N., Kikuchi H., Masuho Y., Yamashita R., Nakai K., Yada T., Nakamura Y., Ohara O., Isogai T., Sugano S.Nat. Genet. 36:40-45(2004) Human chromosome 11 DNA sequence and analysis including novel gene identification.Taylor T.D., Noguchi H., Totoki Y., Toyoda A., Kuroki Y., Dewar K., Lloyd C., Itoh T., Takeda T., Kim D.-W., She X., Barlow K.F., Bloom T., Bruford E., Chang J.L., Cuomo C.A., Eichler E., FitzGerald M.G., Jaffe D.B., LaButti K., Nicol R., Park H.-S., Seaman C., Sougnez C., Yang X., Zimmer A.R., Zody M.C., Birren B.W., Nusbaum C., Fujiyama A., Hattori M., Rogers J., Lander E.S., Sakaki Y.Nature 440:497-500(2006)
NCBI and Uniprot Product Information
NCBI GI #
NCBI GeneID
NCBI Accession #
NCBI GenBank Nucleotide #
Molecular Weight
62.4 kDa
NCBI Official Full Name
histone acetyltransferase KAT5 isoform 4
NCBI Official Synonym Full Names
K(lysine) acetyltransferase 5
NCBI Official Symbol
KAT5
NCBI Official Synonym Symbols
TIP; ESA1; PLIP; TIP60; cPLA2; HTATIP; ZC2HC5; HTATIP1
NCBI Protein Information
histone acetyltransferase KAT5
UniProt Protein Name
Histone acetyltransferase KAT5
UniProt Gene Name
KAT5
UniProt Synonym Gene Names
HTATIP; TIP60; Tip60; HIV-1 Tat interactive protein
UniProt Entry Name
KAT5_HUMAN
Customer Reviews
Loading reviews...
Share Your Experience
Similar Products
Product Notes
The KAT5 kat5 (Catalog #AAA116139) is a Recombinant Protein produced from E Coli and is intended for research purposes only. The product is available for immediate purchase. The immunogen sequence is 3-513. Partial. The amino acid sequence is listed below: EVGEIIEGCR LPVLRRNQDN EDEWPLAEIL SVKDISGRKL FYVHYIDFNK RLDEWVTHER LDLKKIQFPK KEAKTPTKNG LPGSRPGSPE REVPASAQAS GKTLPIPVQI TLRFNLPKER EAIPGGEPDQ PLSSSSCLQP NHRSTKRKVE VVSPATPVPS ETAPASVFPQ NGAARRAVAA QPGRKRKSNC LGTDEDSQDS SDGIPSAPRM TGSLVSDRSH DDIVTRMKNI ECIELGRHRL KPWYFSPYPQ ELTTLPVLYL CEFCLKYGRS LKCLQRHLTK CDLRHPPGNE IYRKGTISFF EIDGRKNKSY SQNLCLLAKC FLDHKTLYYD TDPFLFYVMT EYDCKGFHIV GYFSKEKEST EDYNVACILT LPPYQRRGYG KLLIEFSYEL SKVEGKTGTP EKPLSDLGLL SYRSYWSQTI LEILMGLKSE SGERPQITIN EISEITSIKK EDVISTLQYL NLINYYKGQY ILTLSEDIVD GHERAMLKRL LRIDSKCLHF TPKDWSKRGK W. It is sometimes possible for the material contained within the vial of "Histone acetyltransferase KAT5, Recombinant Protein" to become dispersed throughout the inside of the vial, particularly around the seal of said vial, during shipment and storage. We always suggest centrifuging these vials to consolidate all of the liquid away from the lid and to the bottom of the vial prior to opening. Please be advised that certain products may require dry ice for shipping and that, if this is the case, an additional dry ice fee may also be required.Precautions
All products in the AAA Biotech catalog are strictly for research-use only, and are absolutely not suitable for use in any sort of medical, therapeutic, prophylactic, in-vivo, or diagnostic capacity. By purchasing a product from AAA Biotech, you are explicitly certifying that said products will be properly tested and used in line with industry standard. AAA Biotech and its authorized distribution partners reserve the right to refuse to fulfill any order if we have any indication that a purchaser may be intending to use a product outside of our accepted criteria.Disclaimer
Though we do strive to guarantee the information represented in this datasheet, AAA Biotech cannot be held responsible for any oversights or imprecisions. AAA Biotech reserves the right to adjust any aspect of this datasheet at any time and without notice. It is the responsibility of the customer to inform AAA Biotech of any product performance issues observed or experienced within 30 days of receipt of said product. To see additional details on this or any of our other policies, please see our Terms & Conditions page.Item has been added to Shopping Cart
If you are ready to order, navigate to Shopping Cart and get ready to checkout.